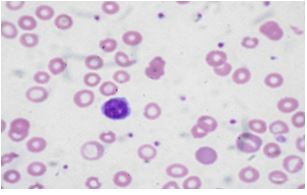

Case Details
An 18 –year- old female reported to the physician for consultation. She complained of generalized weakness, lethargy, and inability to do the routine work from the previous few months. On further questioning, she revealed that she was having excessive bleeding during menstruation for the previous six months. She complained of breathlessness and palpitations while climbing stairs for her house. She also had experienced periods of light-headedness, though not to the point of fainting. Other changes she had noticed were cramping in her legs, a desire to crunch on ice, There was no history of any fever, drug intake or abdominal discomfort. Her appetite had also decreased and she was taking meals only once a day.
Upon examination, her physician found that she had tachycardia, pale gums, and nail beds, and her tongue was swollen. Given her history and the findings on her physical examination, the physician suspected that the patient was anemic and ordered a sample of her blood for examination. The results were as shown below:
Red Blood Cell Count -3.5 million/mm3
Hemoglobin (Hb) -7 g/dl
Hematocrit (Hct)- 30%
Serum Iron – low
Mean Corpuscular Volume (MCV) – low
Mean Corpuscular Hb Concentration (MCHC)- low
Total Iron Binding Capacity in the Blood (TIBC)- high
What is the cause of anemia in this patient?
What are the possible complications in the untreated cases?
Case Discussion- The most likely diagnosis is iron deficiency anemia.
Generalized weakness, exercise intolerance, dyspnea, palpitations, history of blood loss during menstruation, tachycardia and low Hb, all are suggestive of iron deficiency anemia. Iron deficiency is the most prevalent single deficiency state on a worldwide basis. Iron deficiency is related in part to abnormal iron metabolism
Overview of iron metabolism
The balance of iron in humans is tightly controlled and designed to conserve iron for reutilization. There is no regulated excretory pathway for iron, and the only mechanisms by which iron is lost from the body are blood loss (via gastrointestinal bleeding, menses, or other forms of bleeding) and the loss of epithelial cells from the skin, gut, and genitourinary tract. Normally, the only route by which iron comes into the body is via absorption from food or from medicinal iron taken orally. Iron may also enter the body through red-cell transfusions or injection of iron complexes. The margin between the amount of iron available for absorption and the requirement for iron in growing infants and the adult female is narrow; this accounts for the great prevalence of iron deficiency worldwide—currently estimated at one-half billion people.
Iron requirement
The amount of iron required from the diet to replace losses averages about 10% of body iron content a year in men and 15% in women of childbearing age. Dietary iron content is closely related to total caloric intake (approximately 6 mg of elemental iron per 1000 calories). Iron bioavailability is affected by the nature of the foodstuff, with heme iron (e.g., red meat) being most readily absorbed. Certain foodstuffs that include phytates and phosphates reduce iron absorption by about 50%.
Infants, children, and adolescents may be unable to maintain normal iron balance because of the demands of body growth and lower dietary intake of iron. During the last two trimesters of pregnancy, daily iron requirements increase to 5–6 mg. That is the reason why iron supplements are strongly recommended for pregnant women in developed countries.
Iron absorption
Iron absorption takes place largely in the proximal small intestine and is a carefully regulated process. In general, there is no regulation of the amounts of nutrients absorbed from the gastrointestinal tract. A notable exception is an iron, the reason that absorption must be carefully regulated is that the body does not possess a physiological mechanism to eliminate much iron from the body. The small amount of iron that is lost each day (about 1-2 mg) is matched by dietary absorption of iron.
Mechanism of iron absorption
Iron is found in the diet is present as ionic (non-haem) iron and haem iron. Absorption of these two forms of iron occurs by different mechanisms. Absorption is a multistep process involving the uptake of iron from the intestinal lumen across the apical cell surface of the villus enterocytes and the transfer out of the enterocyte across the basolateral membrane to the plasma. Ionic iron is present in the reduced (ferrous) or oxidized (ferric) state in the diet and the first step in the uptake of ionic iron involves the reduction of iron. Recently, a reductase that is capable of reducing iron from its ferric to ferrous state has been identified. It is a membrane-bound haem protein called Dcytb that is expressed in the brush border of the duodenum. Next, ferrous ion is transported across the lumen cell surface by a transporter called divalent metal transporter 1 (DMT1) that can transport a number of other metal ions including copper, cobalt, zinc, and lead.
Once inside the gut cell, iron may be stored as ferritin or transported through the cell to be released at the basolateral surface to plasma transferrin through the membrane-embedded iron exporter, ferroportin. The function of ferroportin is negatively regulated by hepcidin, the principal iron regulatory hormone. More the Hepcidin levels lesser is the iron absorption and vice versa. In the process of release, iron interacts with another ferroxidase, hephaestin, which oxidizes the iron to the ferric form for transferrin binding. Hephaestin is similar to ceruloplasmin, the copper-carrying protein.

Figure- 1-Showing the mechanism of iron absorption
Factors affecting iron absorption
Iron absorption is influenced by a number of physiologic states.
1) Erythroid hyperplasia stimulates iron absorption, even in the face of normal or increased iron stores, and in this state hepcidin levels are inappropriately low. The molecular mechanism underlying this relationship is not known. Thus, patients with anemias associated with high levels of ineffective erythropoiesis absorb excess amounts of dietary iron. Over time, this may lead to iron overload and tissue damage. In iron deficiency, hepcidin levels are low and iron is much more efficiently absorbed from a given diet; the contrary is true in states of secondary iron overload.
2) Hypoxia-Both the rate of erythropoiesis and hypoxia regulate iron absorption. Expression of ferroportin and Dcytb are increased in hypoxia, resulting in more iron absorption.
3) Body Stores– Iron absorption is stimulated if the level in body stores is low.
Hepcidin is produced by hepatocytes when iron stores are full, hepcidin makes a complex with ferroportin resulting in its degradation and thus iron is not transported to the blood and remains in the enterocyte in the form of ferritin.
4) Interfering substances- Iron absorption is decreased by phytic acid (in cereals) and oxalic acid(in leafy vegetables) due to the formation of insoluble salts.
5) Other Minerals- Calcium, copper, zinc, lead, and phosphates also inhibit iron absorption
6) Inflammation can also stimulate hepcidin production resulting in lower iron absorption.
Free Iron toxicity
Iron is a critical element in the function of all cells, although the amount of iron required by individual tissues varies during development. At the same time, the body must protect itself from free iron, which is highly toxic in that it participates in chemical reactions that generate free radicals such as singlet O2 or OH–. Consequently, elaborate mechanisms have evolved that allow the iron to be made available for physiologic functions while at the same time conserving this element and handling it in such a way that toxicity is avoided.
Iron Transport
Iron absorbed from the diet or released from stores circulates in the plasma bound to transferrin, the iron transport protein. Transferrin (Tf) is a bilobed glycoprotein with two iron binding sites. Tf is normally about one-third saturated with iron Transferrin that carries iron exists in two forms—monoferric (one iron atom) or diferric (two iron atoms).
The turnover (half-clearance time) of transferrin-bound iron is very rapid—typically 60–90 min. The half-clearance time of iron in the presence of iron deficiency is as short as 10–15 min. With the suppression of erythropoiesis, the plasma iron level typically increases and the half-clearance time may be prolonged to several hours.
The iron-transferrin complex circulates in the plasma until it interacts with specific transferrin receptors on the surface of marrow erythroid cells. Diferric transferrin has the highest affinity for transferrin receptors; apo transferrin (transferrin not carrying iron) has very little affinity. While transferrin receptors are found on cells in many tissues within the body—and all cells at some time during development will display transferrin receptors—the cell having the greatest number of receptors (300,000 to 400,000/cell) is the developing erythroblast.
Utilization of iron
Once the iron-bearing transferrin interacts with its receptor, the complex is internalized via clathrin-coated pits and transported to an acidic endosome, where the iron is released at a low pH. The iron is then made available for heme synthesis while the transferrin-receptor complex is recycled to the surface of the cell, where the bulk of the transferrin is released back into circulation and the transferrin receptor re anchors in to the cell membrane. At this point, a certain amount of the transferrin receptor protein may be released into circulation and can be measured as soluble transferrin receptor protein. Within the erythroid cell, iron in excess of the amount needed for hemoglobin synthesis binds to a storage protein, apoferritin, forming ferritin. This mechanism of iron exchange also takes place in other cells of the body expressing transferrin receptors, especially liver parenchymal cells where the iron can be incorporated into heme-containing enzymes or stored. The iron incorporated into hemoglobin subsequently enters the circulation as new red cells are released from the bone marrow. The iron is then part of the red cell mass and will not become available for reutilization until the red cell dies.

Figure-2 showing the internalization of Iron- Transferrin complex, utilization of iron and transport to other cells via Transferrin from the hepatocyte
Conservation of iron
In a normal individual, the average red cell life span is 120 days. Thus, 0.8–1.0% of red cells turn over each day. At the end of its life span, the red cell is recognized as senescent by the cells of the reticuloendothelial (RE) system, and the cell undergoes phagocytosis. Once within the RE cell, the hemoglobin from the ingested red cell is broken down, the globin and other proteins are returned to the amino acid pool, and the iron is shuttled back to the surface of the RE cell, where it is presented to circulating transferrin. It is the efficient and highly conserved recycling of iron from senescent red cells that supports steady state (and even mildly accelerated) erythropoiesis. Persistent errors in iron balance lead to either iron deficiency anemia or hemosiderosis. Both are disorders with potential adverse consequences.
Storage of iron
Ferritin and Haemosiderin are iron-containing compounds meant for the storage of iron. Ferritin is a protein-bound, water-soluble, mobilizable storage compound and is the major source of storage iron. Haemosiderin is a water-insoluble form that is less readily available for use. When the amount of total body iron is relatively low, storage iron consists predominately of ferritin. When iron stores are high, Haemosiderin predominates. Unlike ferritin, Haemosiderin stains with the Prussian blue stain (Pens reaction) and may be observed in tissues. Storage forms normally comprise approximately 30% of total body iron. Iron stores provide a source of iron when physiologic demand is high, e.g., blood loss, pregnancy, and periods of rapid growth.
The metabolic role of iron
Iron is vital for all living organisms because it is essential for multiple metabolic processes, including oxygen transport, DNA synthesis, and electron transport.
The major role of iron in mammals is to carry O2 as part of hemoglobin. O2 is also bound by myoglobin in muscle. Iron is a critical element in iron-containing enzymes, including the cytochrome system in mitochondria. Without iron, cells lose their capacity for electron transport and energy metabolism. In erythroid cells, hemoglobin synthesis is impaired, resulting in anemia and reduced O2 delivery to tissue.
Iron-containing Proteins
a) Haem containing proteins
Hemoglobin, Myoglobin, Cytochromes, Catalase, Peroxidase, Lactoperoxidase and tryptophan pyrrolase
b) Non-haem containing proteins
Aconitase, Phenyl alanine hydroxylase, Transferrin, Ferritin, and hemosiderin
c) Iron-sulfur complexes
Adrenodoxin, Complex-III of Electron transport chain, Succinate dehydrogenase and Xanthine oxidase
Demand and supply imbalance
Since each milliliter of red cells contains 1 mg of elemental iron, the amount of iron needed to replace those red cells lost through senescence amounts to 16–20 mg/d (assuming an adult with a red cell mass of 2 L). Any additional iron required for daily red cell production comes from the diet. Normally, an adult male will need to absorb at least 1 mg of elemental iron daily to meet needs, while females in the childbearing years will need to absorb an average of 1.4 mg/d. However, to achieve a maximum proliferative erythroid marrow response to anemia, additional iron must be available. With markedly stimulated erythropoiesis, demands for iron are increased by as much as six- to eightfold. With extravascular hemolytic anemia, the rate of red cell destruction is increased, but the iron recovered from the red cells is efficiently reutilized for hemoglobin synthesis. In contrast, with intravascular hemolysis or blood loss anemia, the rate of red cell production is limited by the amount of iron that can be mobilized from stores. Typically, the rate of mobilization under these circumstances will not support red cell production more than 2.5 times normal. If the delivery of iron to the stimulated marrow is suboptimal, the marrow’s proliferative response is blunted, and hemoglobin synthesis is impaired. The result is a hypoproliferative marrow accompanied by microcytic, hypochromic anemia.
Menstrual blood loss in women plays a major role in iron metabolism. The average monthly menstrual blood loss is approximately 50 mL, or about 0.7 mg/d. However, menstrual blood loss maybe five times the average. To maintain adequate iron stores, women with heavy menstrual losses must absorb 3–4 mg of iron from the diet each day. This strains the upper limit of what may reasonably be absorbed, and women with menorrhagia of this degree will almost always become iron deficient without iron supplementation.
Pregnancy may also upset the iron balance since requirements increase to 2–5 mg of iron per day during pregnancy and lactation. Normal dietary iron cannot supply these requirements, and medicinal iron is needed during pregnancy and lactation. Repeated pregnancy (especially with breast-feeding) may cause iron deficiency if increased requirements are not met with supplemental medicinal iron.
Decreased iron absorption can on very rare occasions cause iron deficiency and usually occurs after gastric surgery, though concomitant bleeding is frequent.
By far the most important cause of iron deficiency anemia is blood loss, especially gastrointestinal blood loss. Chronic aspirin use may cause it even without a documented structural lesion. Iron deficiency demands a search for a source of gastrointestinal bleeding if other sites of blood loss (menorrhagia, other uterine bleeding, and repeated blood donations) are excluded.
Chronic hemoglobinuria may lead to iron deficiency since iron is lost in the urine; traumatic hemolysis due to a prosthetic cardiac valve and other causes of intravascular hemolysis (eg, paroxysmal nocturnal hemoglobinuria) should also be considered. Frequent blood donors may also be at risk for iron deficiency.
While blood loss or hemolysis places a demand on the iron supply, conditions associated with inflammation interfere with iron release from stores and can result in a rapid decrease in the serum iron level.
Summary of Causes of Iron Deficiency
Conditions that increase demand for iron, increase iron loss, or decrease iron intake or absorption can produce iron deficiency;
- Increased demand for iron and/or hematopoiesis
- rapid growth in infancy or adolescence
- pregnancy
- erythropoietin therapy
- Increased iron loss
- chronic blood loss
- menses
- acute blood loss
- blood donation
- Phlebotomy as a treatment for polycythemia vera.
- Decreased iron intake or absorption
- inadequate diet
- malabsorption from disease (sprue, Crohn’s disease)
- malabsorption from surgery (post-gastrectomy)
- acute or chronic inflammation
Iron deficiency anemia
Iron deficiency is defined as decreased total iron body content. Iron deficiency anemia occurs when iron deficiency is sufficiently severe to diminish erythropoiesis and cause the development of anemia. Iron deficiency is the most prevalent single deficiency state on a worldwide basis. It is important economically because it diminishes the capability of individuals who are affected to perform physical labor, and it diminishes both growth and learning in children.
Frequency
In countries where little meat is in the diet, iron deficiency anemia is 6-8 times more prevalent. This occurs despite the consumption of a diet that contains an equivalent amount of total dietary iron because heme iron is absorbed better from the diet than nonheme iron. In certain geographic areas, intestinal parasites, particularly hookworm, worsen the iron deficiency because of blood loss from the gastrointestinal tract. Anemia is more profound among children and premenopausal women in these environments.
Mortality/Morbidity
Chronic iron deficiency anemia is seldom a direct cause of death; however, moderate or severe iron deficiency anemia can produce sufficient hypoxia to aggravate underlying pulmonary and cardiovascular disorders. In children, the growth rate may be slowed, and a decreased capability to learn is reported.
Clinical Manifestations
As a rule, the only symptoms of iron deficiency anemia are those of the anemia itself (easy fatigability, tachycardia, palpitations, and tachypnea on exertion). Severe deficiency causes skin and mucosal changes, including a smooth tongue, brittle nails, and cheilosis. Dysphagia because of the formation of esophageal webs (Plummer–Vinson syndrome) also occurs. Many iron-deficient patients develop pica, craving for specific foods (ice chips, etc) often not rich in iron.
Laboratory Findings
- CBC count
- This documents the severity of the anemia. In chronic iron deficiency anemia, the cellular indices show a microcytic and hypochromic erythropoiesis, ie, both the mean corpuscular volume (MCV) and mean corpuscular hemoglobin concentration (MCHC) have values below the normal range for the laboratory performing the test. Reference range values for the MCV and MCHC are 83-97 fL and 32-36 g/dL, respectively.
- Often, the platelet count is elevated (>450,000/µL). This normalizes following iron therapy.
- The WBC count is usually within reference ranges (4500-11,000/µL).
- If the CBC count is obtained after blood loss, the cellular indices do not enter the abnormal range until most of the erythrocytes produced before the bleed are destroyed at the end of their normal lifespan (120 d).
- Peripheral smear
- In the early stages, the MCV remains normal. Subsequently, the MCV falls and the blood smear shows hypochromic microcytic cells (see blood smear). With further progression, anisocytosis (variations in red blood cell size) and poikilocytosis (variation in the shape of red cells) develop. Severe iron deficiency will produce a bizarre peripheral blood smear, with severely hypochromic cells, target cells, hypochromic pencil-shaped cells, and occasionally small numbers of nucleated red blood cells. The platelet count is commonly increased.(Figure-3)
- Combined folate deficiency and iron deficiency are commonplace in areas of the world with little fresh produce and meat. The peripheral smear reveals a population of macrocytes mixed among the microcytic hypochromic cells. This combination can normalize the MCV.
Figure –3- showing microcytic hypochromic cells in peripheral smear
- Serum iron, total iron-binding capacity (TIBC), and serum ferritin: Iron deficiency develops in stages. The first is depletion of iron stores. At this point, there is anemia and no change in red blood cell size. The serum ferritin will become abnormally low. A ferritin value less than 30 mcg/L is a highly reliable indicator of iron deficiency. The serum total iron-binding capacity (TIBC) rises. After iron stores have been depleted, red blood cell formation will continue with deficient supplies of iron. Serum iron values decline to less than 30 mcg/dL and transferrin saturation to less than 15%. A low serum iron and ferritin with an elevated TIBC are diagnostic of iron deficiency. While low serum ferritin is virtually diagnostic of iron deficiency, a normal serum ferritin can be seen in patients who are deficient in iron and have coexistent diseases (hepatitis, anemia of chronic disorders). These test findings are useful in distinguishing iron deficiency anemia from other microcytic anemias
- A bone marrow aspirate can be diagnostic of iron deficiency. Bone marrow biopsy for evaluation of iron stores is now rarely performed because of variation in its interpretation.
- Other laboratory tests are useful to establish the etiology of iron deficiency anemia and to exclude or establish a diagnosis of 1 of the other microcytic anemias.
- Testing stool for the presence of hemoglobin is useful in establishing gastrointestinal bleeding as the etiology of iron deficiency anemia. Severe iron deficiency anemia can occur in patients with a persistent loss of less than 20 mL/d.
- Hemoglobinuria and hemosiderinuria can be detected by laboratory testing. This documents iron deficiency to be due to renal loss of iron and incriminates intravascular hemolysis as the etiology.
- Hemoglobin electrophoresis and measurement of hemoglobin A2 and fetal hemoglobin are useful in establishing either beta-thalassemia or hemoglobin C or D as the etiology of the microcytic anemia.
- Serum Levels of Transferrin Receptor Protein-Because erythroid cells have the highest numbers of transferrin receptors on their surface of any cell in the body, and because transferrin receptor protein (TRP) is released by cells into the circulation, serum levels of TRP reflect the total erythroid marrow mass. Another condition in which TRP levels are elevated is absolute iron deficiency. Normal values are 4–9 μg/L determined by immunoassay. This laboratory test is becoming increasingly available and, along with the serum ferritin, has been proposed to distinguish between iron deficiency and the anemia of chronic inflammation
Differential Diagnosis
Other causes of microcytic anemia include anemia of chronic disease, thalassemia, and sideroblastic anemia. Anemia of chronic disease is characterized by normal or increased iron stores in the bone marrow and a normal or elevated ferritin level; the serum iron is low, often drastically so, and the TIBC is either normal or low. Thalassemia produces a greater degree of microcytosis for any given level of anemia than does iron deficiency. Red blood cell morphology on the peripheral smear is abnormal earlier in the course of thalassemia.
Treatment
The diagnosis of iron deficiency anemia can be made either by the laboratory demonstration an iron-deficient state or evaluating the response to a therapeutic trial of iron replacement.
Since the anemia itself is rarely life-threatening, the most important part of treatment is the identification of the cause—especially a source of occult blood loss.
Oral Iron
Ferrous sulfate, 325 mg three times daily, which provides 180 mg of iron daily of which up to 10 mg is absorbed (through absorption may exceed this amount in cases of severe deficiency), is the preferred therapy.
Parenteral Iron
The indications are intolerance to oral iron, refractoriness to oral iron, gastrointestinal disease (usually inflammatory bowel disease) precluding the use of oral iron, and continued blood loss that cannot be corrected. Because of the possibility of anaphylactic reactions, parenteral iron therapy should be used only in cases of persistent anemia after a reasonable course of oral therapy.
Red Cell Transfusion
Transfusion therapy is reserved for individuals who have symptoms of anemia, cardiovascular instability, continued and excessive blood loss from whatever source, and require immediate intervention. The management of these patients is less related to iron deficiency than it is to the consequences of the severe anemia. Not only do transfusions correct the anemia acutely, but the transfused red cells provide a source of iron for reutilization, assuming they are not lost through continued bleeding. Transfusion therapy will stabilize the patient while other options are reviewed.
Prognosis
Iron deficiency anemia is an easily treated disorder with an excellent outcome; however, it may be caused by an underlying condition with a poor prognosis, such as neoplasia. Similarly, the prognosis may be altered by a comorbid condition such as coronary artery disease.




